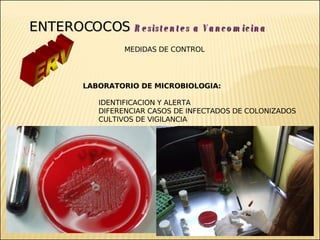
Brote Hospitalario de Infecciones Multirresistentes
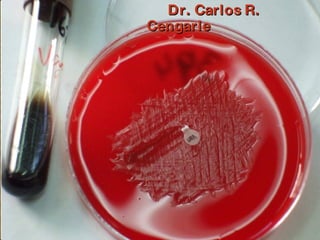
Brote Hospitalario de Infecciones Multirresistentes

Incrustar presentación




















































































































































El documento discute la resistencia a los antibióticos y la aparición y propagación de bacterias multirresistentes en los hospitales. Explica que las bacterias desarrollan resistencia a través de mutaciones genéticas, el intercambio de genes entre especies, y el uso inadecuado de antibióticos. También destaca la importancia del laboratorio de microbiología para la detección y vigilancia de estas bacterias mediante cultivos y la comunicación de patrones de resistencia.